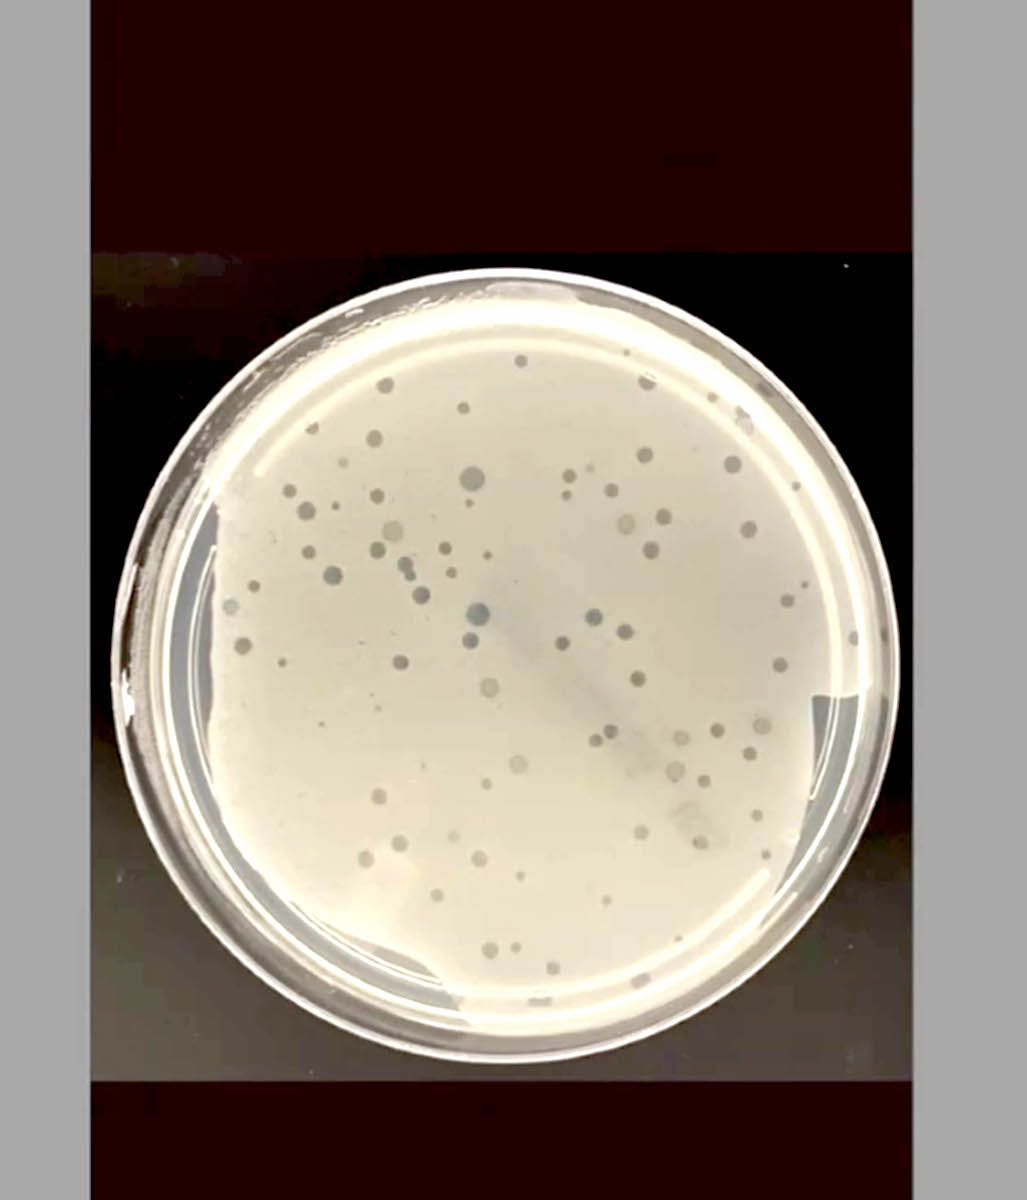

Cada año se registra cerca de un millón de muertes a nivel mundial a causa de la resistencia antimicrobiana
Ciudad de México, 15 de julio de 2023.- Debido a que cada vez es mayor la cantidad de bacterias multirresistentes a antibióticos, científicos de la UNAM estudian virus denominados bacteriófagos o fagos, los cuales son “depredadores” de ellas.
El investigador del Centro de Ciencias Genómicas (CCG), Víctor Manuel González Zúñiga, explicó que en el laboratorio aislaron múltiples bacteriófagos a fin de conocer cómo actúan para infectar a las bacterias y, de esta manera, tratar de hacer frente a la resistencia antimicrobiana, que de acuerdo con estudios recientes causa cerca de un millón de muertes al año, en el mundo.
“Los fagos son elementos biológicos que se introducen en la bacteria, se enlazan a la membrana celular y transfieren su ADN al interior de la célula donde se replican. Al replicarse, expresan una serie de proteínas y se reproducen, se hacen miles de bacteriófagos dentro de la célula y terminan matándola. Por ello se les conoce como ‘depredadores’, pues son muy efectivos para eliminar una bacteria”, expuso el experto universitario.
Cualquier bacteria en el orbe, ya sea benéfica o patógena, tiene asociados bacteriófagos. Son virus pequeños, del orden de nanómetros, que acarrean material genético que incluso puede serle útil a la célula bacteriana, como toxinas y otros genes de virulencia y resistencia a antibióticos, detalló.
Estos estudios, comentó González Zúñiga, comenzaron hace más de un siglo con el investigador franco canadiense Félix Hubert d’Herelle y derivaron en el uso de bacteriófagos contra la Shigella, la Salmonella y diversas bacterias intestinales. Los trabajos pioneros se realizaron, en su mayoría, en los países de la exUnión Soviética.
Sin embargo, en occidente se abandonaron ante el “boom” de los antibióticos y sólo se continuaron en países que estaban bajo el régimen soviético. Actualmente existe el Instituto Eliava, en Georgia, que produce y comercializa materiales a base de fagos para combatir, por ejemplo, enfermedades gastrointestinales.
Hoy en día, prosiguió el experto, en diversas universidades del mundo han retomado estas investigaciones a las que se le denomina “terapia de fagos, alternativa a los antibióticos”.
En el caso del CCG se estudian fagos para dos bacterias de importancia clínica: Staphylococcus aureus y Acinetobacter baumannii, a partir de muestras obtenidas de hospitales de la Ciudad de México.
Infecciones nosocomiales
El integrante del Programa de Genómica Evolutiva del CCG abundó que se eligió trabajar en fagos contra las bacterias de S. aureus y A. baumannii porque son oportunistas y representan una amenaza para pacientes hospitalizados.
La S. aureus comúnmente se encuentra en garganta, nariz y piel sin causar daño. Sin embargo, en los nosocomios afecta a personas enfermas y coloniza lugares en los que no debe estar, como el corazón, el intestino y puede causar septicemias.
“También se ha encontrado en pacientes con válvulas cardíacas, prótesis, pues tiene varias propiedades que la hacen muy virulenta y se puede pegar a superficies y desarrollar una película que hace que los antibióticos no la penetren de manera eficaz”, alertó.
La A. baumannii de ambientes hospitalarios es peligrosa porque es flexible en cuanto a la adquisición de elementos genéticos móviles; es decir, de segmentos de ADN. “Se pueden transferir entre bacterias, genes de virulencia y genes de resistencia a antibióticos, lo que la hace doblemente importante”, añadió el especialista de la UNAM.
De acuerdo con González Zúñiga, el objetivo es buscar los fagos más adecuados para atacar a las bacterias multirresistentes a los antibióticos, y combatirlas cuando ya no hay antibiótico que las elimine.
Esta tecnología es aún incipiente, pero en la literatura médica hay casos exitosos de su aplicación y es muy prometedora. “Seguramente en algunos años más podremos contar con algunos productos que provengan de bacteriófagos y sean efectivos contra las infecciones bacterianas que no se pueden combatir con antibióticos”, precisó el universitario.
Actualmente, dijo, se han desarrollado protocolos para atender a pacientes con esta terapia alternativa, cuando no hay otro recurso de tratamiento. La mayoría de estos casos se han registrado en Estados Unidos y Reino Unido, donde han surgido experiencias exitosas.
Abundantes en la naturaleza
La investigación sobre los fagos es compleja. No termina con aislar un bacteriófago apto para combatir una bacteria, también se les puede modificar mediante ingeniería genética y que sean más específicos para una bacteria en particular.
“El problema siempre es encontrar cuál es el bacteriófago más adecuado en un conjunto amplio de candidatos”, resaltó González Zúñiga.
Se estima que los fagos son los elementos biológicos más abundantes en la naturaleza, que hay aproximadamente 10 por cada bacteria existente, aunque esta proporción varía, según el ambiente en que se encuentren: suelo, ambiente marino, intestino humano o cualquier otro.
El especialista universitario advirtió que las bacterias también pueden desarrollar resistencia a los fagos, ya que es posible que muten en su pared celular y no los dejen penetrar.
Por ello, no debe usarse solo uno, sino “un cóctel” de dos, tres o más para asegurar que, si es resistente a alguno, haya otro que pueda aniquilarla.
González Zúñiga recordó que hay fagos que permanecen dentro de los genomas de las bacterias “como durmiendo, sin tener ninguna actividad aparente” y pueden vivir así por muchas generaciones, junto con los demás genes de la bacteria. Se les conoce como profagos.
En ocasiones estas portadoras de profagos colonizan ambientes hostiles para su crecimiento, como sitios que carecen de nutrientes, presencia de agentes químicos dañinos, o radiaciones. Allí se activan sus sistemas de alarma, de reparación de ADN, por lo que el fago empieza a reproducirse, sale de la bacteria y la elimina.
“El juego evolutivo entre la bacteria y el bacteriófago es de nunca acabar: el bacteriófago puede alterarse, desarrollar sistemas de infección mucho más sofisticados, evolucionar, pero también la bacteria tiene un sistema de defensa para no ser infectada”, afirmó.
El experto universitario sugirió tomar conciencia de que la resistencia antimicrobiana es un grave problema ante el cual no existe una sola solución: se debe hacer demasiado trabajo de prevención, aplicar los agentes antimicrobianos de manera racional y complementaria a otras estrategias como las de los bacteriófagos, para que pudieran ser efectivos. “No hay una sola solución, pero hay que avanzar; sobre todo, en la prevención, que eso sí está en las manos de todos”.
Descubre más desde
Suscríbete y recibe las últimas entradas en tu correo electrónico.
